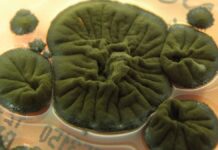
Чорнобильський гриб: як радіація може стати джерелом їжі

Відчуття плину часу — відчуття, що події течуть із майбутнього в теперішнє до минулого — глибоко вкорінене в людському досвіді. Ми говоримо, що час «летить» або «нікого не чекає», ніби це відчутна сила. Однак це сприйняття може бути не відображенням зовнішньої правди, а скоріше тим, як наш розум інтерпретує реальність. Філософські та наукові дослідження показують, що час, як ми його відчуваємо, не є фундаментальним аспектом Всесвіту, а радше психологічною проекцією.
Стародавній скептицизм і сучасна фізика
Питання про природу часу не нові. Стародавні філософи, такі як Парменід, ставили під сумнів саму ідею зміни, запитуючи, як щось може перейти від неіснування (майбутнього) до буття (сьогодення) без протиріч. Століттями пізніше Ісаак Ньютон припустив, що час є універсальною, текучою сутністю, об’єктивним годинником, який відстежує плин часу у всьому Всесвіті.
Але теорії відносності Альберта Ейнштейна зруйнували цю ідею. Теорія відносності довела, що час є не абсолютним, а відносною системи відліку спостерігача. Швидкість світла залишається постійною незалежно від руху, а це означає, що два спостерігачі, які рухаються з різними швидкостями, сприйматимуть час по-різному. Удар блискавки, який є одночасним для однієї людини, може відбутися в інший час для іншої – ніхто не є “неправильний”, просто по-іншому розташований у просторі-часі.
З цього випливає радикальний висновок: згідно з теорією відносності, усі моменти часу рівні. Минуле, теперішнє і майбутнє не течуть; вони просто існують. Ця концепція, відома як етерналізм, широко прийнята як у фізиці, так і у філософії. Якщо нічого принципово не зміниться, то відчуття плину часу має прийти звідкись.
Ілюзія проходу: проекція, а не спотворення
Одне з поширених пояснень називає плин часу «ілюзією», маючи на увазі, що наш мозок просто обдурили. Однак більш точне формулювання припускає, що це помилка сприйняття – когнітивна помилка в тому, як ми інтерпретуємо досвід.
Зважайте на колір: троянда від природи не червона; він відбиває світло певної довжини хвилі, викликаючи візуальне враження, яке ми називаємо «червоністю». Краса не в троянді, а в нашому сприйнятті її. Подібним чином плин часу не є властивістю Всесвіту, а побічним продуктом того, як ми структуруємо наші спогади та очікування.
Наш мозок будує розповідь про зміни, згадуючи минулі події та передбачаючи майбутні. Це створює відчуття потоку, хоча час об’єктивно не минає. Відчуття реальні для нас, але не фундаментальні для реальності.
Перспектива і реальність
Подібно до того, як GPS може точно відображати наше місцезнаходження в несвідомому стані, наше сприйняття часу є корисним уявленням, а не абсолютною істиною. Ми не можемо описати світ, не посилаючись на час, так само як ми не можемо описати троянду, не згадавши її колір. Однак сплутати нашу точку зору з реальністю є великою помилкою.
Хід часу нерозривно пов’язаний з тим, як люди розуміють і відчувають світ. Будь-який опис реальності, який ми створюємо, неминуче буде фільтруватися через нашу суб’єктивну точку зору. Визнання цієї різниці дає зрозуміти, що час не є властивістю всесвіту ; це особливість нашого розуму, незамінний інструмент для орієнтування в існуванні.
Зрештою, віра в плин часу — це не викривлення, а необхідна проекція. Це те, як ми розуміємо світ, навіть якщо це розуміння не відповідає основній фізиці.